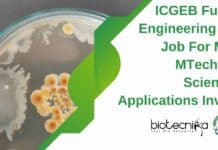
ICGEB Fungal Engineering JRF Job For MSc, MTech Life Sciences, Applications Invited ICGEB JRF For MTech

Turning to the Brain to Reboot Computing
Computation is stuck in a rut. The integrated circuits that powered the past 50 years of technological revolution are reaching their physical limits. This predicament...
Enrol For Biotech Ph.D. Programs – Dec 2016 session @ NIT Warangal
NATIONAL INSTITUTE OF TECHNOLOGY WARANGAL
Admission into Ph.D. Programs for December 2016 session
The Ph.D. Programs, in Full-time (FT) and Part-time (PT) modes, are...
Community Biotech Summit Opens New World To Youth
Shelsy Aragon was nervous. The 14-year-old was standing in front of hundreds of people in a packed room at East Los Angeles College, a microphone hot...
NBRC Invites Applications For Admissions to Ph.D. & M.Sc. (Neuroscience) Programmes – 2017
Admission to Ph.D and M.sc (Neuroscience) Programmes - 2017
NBRC invites applications for admissions to Ph.D. and M.Sc. (Neuroscience) programmes.
Candidates applying for the Ph.D. Programme...
Admissions Open For Ph.D Program in Biological Science @ AcSIR For Jan 2017 Session
AcSIR – Academy of Scientific & Innovative Research
Headquarters : Training and Development Complex, CSIR Campus, CSIR Road, Taramani, Chennai – 600 113
Coordination Office : CSIR – Central...
Healthy Societies: How To Create A Disease-Free City
Chandigarh and Surat, by segregating and storing waste at source and recycling and composting, show other cities the way forward. With even the national capital...
Dr Gerald Cox From Sanofi’s Genzyme Joins CRISPR’s Editas as CMO
Editas Medicine ($EDIT) has nabbed former VP of rare disease clinical development Dr. Gerald Cox from Sanofi’s Genzyme ($SNY) to become its CMO. The...
HDAC Inhibitors Could Wipe Out Breast And Ovarian Cancer Stem Cells
Scientists at the University of Miami have developed a genetically engineered cell line to show that HDAC inhibitors could potentially target and stamp out...
First Evidence: Human Stem Cells Could Decide Cancer ‘Lifestyle’ vs ‘Bad Luck’ Debate
Researchers, funded by UK charity Worldwide Cancer Research, have found that the DNA code of human stem cells acquires errors at a fairly constant...
Can Brain Waves Be Used To Detect Personal Information?
Cyber security and authentication have been under attack in recent months as, seemingly every other day, a new report of hackers gaining access to...
Amgen and Nuevolution Join To Develop Oncology & Neuroscience Treatments
Amgen has agreed to develop and commercialize novel oncology and neuroscience therapies discovered through Nuevolution’s Chemetics® drug discovery platform, through a collaboration that could...
Biocon Founder Kiran Mazumdar-Shaw Backs Two New Cancer Startups
Nearly four decades after launching Biocon, one of India’s earliest biotech companies, Kiran Mazumdar-Shaw is ready to be part of the country’s startup ecosystem.
Recently, she...
Medgenome in Pact to Sequence Genome of 100K People in Asia
Bangalore-based MedGenome Labs Pvt. Ltd, a genomics-based diagnostics and research services firm backed by venture capital firm Sequoia Capital, said it has joined hands...
Instant Analysis: Celgene Pays $600 Million for Swiss Biotech
Celgene is at it again. The acquisitive company agreed to pay $600 million for Switzerland-based EngMab. Privately held EngMab is a biotech that concentrates its...
Global Biotech Firms Are Sure Of Good GM Regulatory Regime In India
Global biotechnology firms are positive about India's robust regulatory regime for approving genetically modified crops, which has started functioning transparently and effectively in recent...